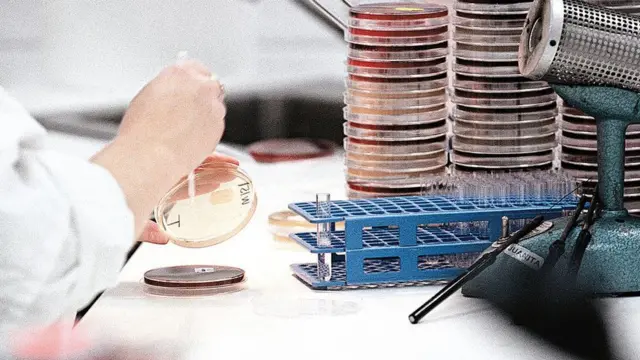
Анализ ДНК

Вас могут выследить по чужой ДНК. Как это возможно

Автор фото, AFP
- Автор, Николай Воронин
- Место работы, Корреспондент по вопросам науки и технологий
- Опубликовано
Представьте, что полиция и спецслужбы могут отследить вас по ДНК, даже если вы никогда в жизни не сдавали соответствующих анализов и уверены, что вас нет ни в одной генетической базе данных. Как бы вы отнеслись к такой перспективе?
Именно так уже обстоят дела в Европе и Северной Америке.
Популярность широко разрекламированных генетических тестов, обещающих рассказать всю правду о происхождении ваших предков и найти дальних родственников, привела к тому, что у предоставляющих их компаний скопились миллионы образцов ДНК, при помощи которых уже можно вычислить практически любого человека европейского происхождения.
Именно так, например, в этом году Калифорнии было раскрыто дело серийного убийцы, личность которого не могли установить на протяжении 40 слишним лет. У полицейских были образцы ДНК преступника, но они были бесполезны: на протяжении десятилетий ни одна база генетических данных не выдавала совпадения результатов.
Тогда они попробовали найти не самого убийцу, а отдаленных членов его семьи, имеющих общих предков в третьем-четвертом поколении. Семейного древа, построенного только на базе открытых источников, хватило для того, чтобы сузить круг подозреваемых до одного конкретного человека. Он и оказался убийцей.

Автор фото, Reuters
С тех пор - только за последние полгода - аналогичным образом в США было раскрыто еще по меньшей мере 13 уголовных дел.
Добровольный анализ
На первый взгляд может показаться, что новый метод лишь пойдет на пользу правоохранительным органам. Однако не стоит забывать, что он целиком основан на открытых источниках, доступ к которым может получить кто угодно.
Поток желающих узнать побольше о своих предках не иссякает - не только в Штатах, но и по всему миру. В России подобные услуги предоставляет уже несколько десятков компаний и частных клиник. Генетические базы данных продолжают расти и становиться все более подробными.
А значит, недалек тот день, когда любой желающий сможет вычислить по ДНК кого угодно - и с какой угодно целью.
К сожалению, эти опасения подтверждаются расчетами ученых.

Автор фото, AFP
На прошлой неделе в журнале Science было опубликовано исследование, в котором утверждается: на основании уже существующих открытых баз данных генетической информации в США не составит особого труда найти любого человека европеоидной расы.
Оно и неудивительно - ведь движимые любопытством и желанием побольше узнать о своих предках, 15 млн американцев добровольно сдали образцы своей ДНК на анализ. Именно США пока являются лидером по количеству проведенных тестов, однако их быстро догоняют другие страны.
"Генетический маяк"
Изучив более миллиона записей, ученые пришли к выводу, что поиск по базе в 60% случаев отыщет вам по меньшей мере одного родственника не дальше четвертого колена - то есть имеющего с вами общего прапрадеда или прапрабабку, - а зачастую и более близкого.
В остальных случаях родственные связи все равно найдутся, но уже более отдаленные. Впрочем, даже на их основе можно выстроить довольно подробное семейное древо, покопавшись в архивах и других источниках.
Калифорнийского убийцу поймали именно так. Полицейские создали фейковый профиль на генеалогическом сайте GEDmatch (это лишь один из десятков подобных сервисов), предоставив образцы ДНК преступника и запустив поиск похожего генетического материала.
Автор фото, Getty Images
"Каждый конкретный человек в базе данных - своеобразный маяк генетической информации, и свет этого маяка позволяет увидеть сотни родственных связей, объединенных одним семейным древом", - цитирует Washington Post Янива Эльриха, ведущего автора исследования, опубликованного в журнале Sceince.
При этом в США три четверти пользователей этой услуги (из 1,28 млн изученных учеными записей) оказались потомками выходцев из Северной Европы.
Стоит базе данных вырасти примерно до 2% населения страны - и, как обещают ученые, две трети запросов будут выдавать вам уже троюродных братьев и сестер, а то и более близких родственников.
Учитывая, что популярность генетических тестов не ослабевает (в том числе в качестве универсального подарка на день рождения), кажется, ждать осталось не так долго.
Хотите узнавать обо всем самом важном и интересном через мессенджер? Тогда подписывайтесь на наш Telegram-канал.


















